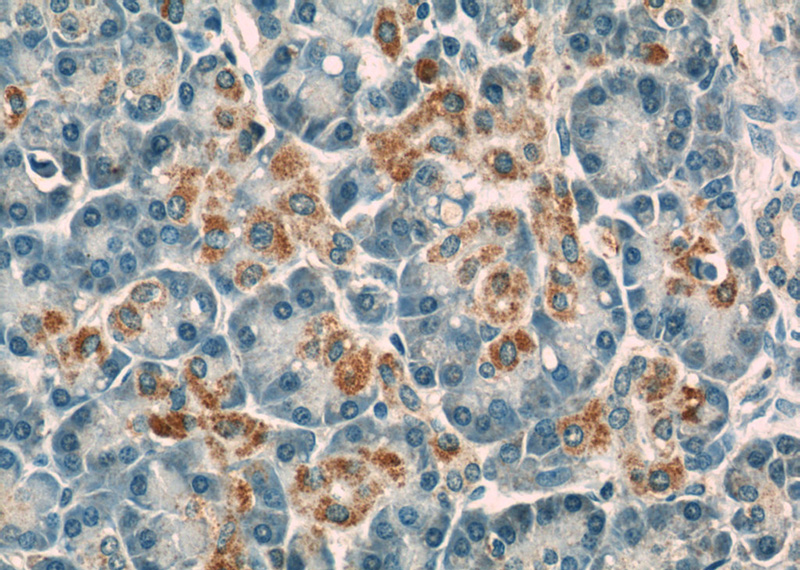
Immunohistochemistry of paraffin-embedded human pancreas slide using Catalog No:108880(CASP9 Antibody) at dilution of 1:50

-
Product Name
Caspase 9/p35/p10 antibody
- Documents
-
Description
Caspase 9/p35/p10 Rabbit Polyclonal antibody. Positive WB detected in HeLa cells, UV treated Hela cells. Positive IF detected in HUVEC cells. Positive IHC detected in human pancreas tissue, human heart tissue. Observed molecular weight by Western-blot: 46 kDa
-
Tested applications
ELISA, WB, IHC, IF
-
Species reactivity
Human; other species not tested.
-
Alternative names
APAF 3 antibody; APAF3 antibody; Apoptotic protease Mch 6 antibody; CASP 9 antibody; CASP9 antibody; Caspase 9 antibody; Caspase 9/p35/p10 antibody; CASPASE 9c antibody; Caspase9 antibody; Caspase-9 antibody; ICE LAP6 antibody; ICE like apoptotic protease 6 antibody; MCH6 antibody
-
Isotype
Rabbit IgG
-
Preparation
This antibody was obtained by immunization of Caspase 9/p35/p10 recombinant protein (Accession Number: NM_001229). Purification method: Antigen affinity purified.
-
Clonality
Polyclonal
-
Formulation
PBS with 0.02% sodium azide and 50% glycerol pH 7.3.
-
Storage instructions
Store at -20℃. DO NOT ALIQUOT
-
Applications
Recommended Dilution:
WB: 1:500-1:5000
IHC: 1:20-1:200
IF: 1:10-1:100
-
Validations

HeLa cells were subjected to SDS PAGE followed by western blot with Catalog No:108880(CASP9 antibody) at dilution of 1:1000

Immunohistochemistry of paraffin-embedded human pancreas slide using Catalog No:108880(CASP9 Antibody) at dilution of 1:50
Immunohistochemistry of paraffin-embedded human pancreas slide using Catalog No:108880(CASP9 Antibody) at dilution of 1:50

Immunofluorescent analysis of HUVEC cells using Catalog No:108880(Caspase 9 Antibody) at dilution of 1:25 and Rhodamine-Goat anti-Rabbit IgG
-
Background
Caspase 9, apoptosis-related cysteine protease (CASP9,synonyms: MCH6, APAF3, APAF-3, ICE-LAP6, CASPASE-9c)is a member of the cysteine-aspartic acid protease (caspase) family. Sequential activation of caspases plays a central role in the execution-phase of cell apoptosis. Caspases exist as inactive proenzymes which undergo proteolytic processing at conserved aspartic residues to produce 2 subunits, large and small, that dimerize to form the active enzyme. CASP9 is processed by caspase APAF1; this step is thought to be one of the earliest in the caspase activation cascade
-
References
- Fu C, Xu D, Wang CY. Alpha-Lipoic Acid Promotes Osteoblastic Formation in H2O2 -Treated MC3T3-E1 Cells and Prevents Bone Loss in Ovariectomized Rats. Journal of cellular physiology. 230(9):2184-201. 2015.
Related Products / Services
Please note: All products are "FOR RESEARCH USE ONLY AND ARE NOT INTENDED FOR DIAGNOSTIC OR THERAPEUTIC USE"
